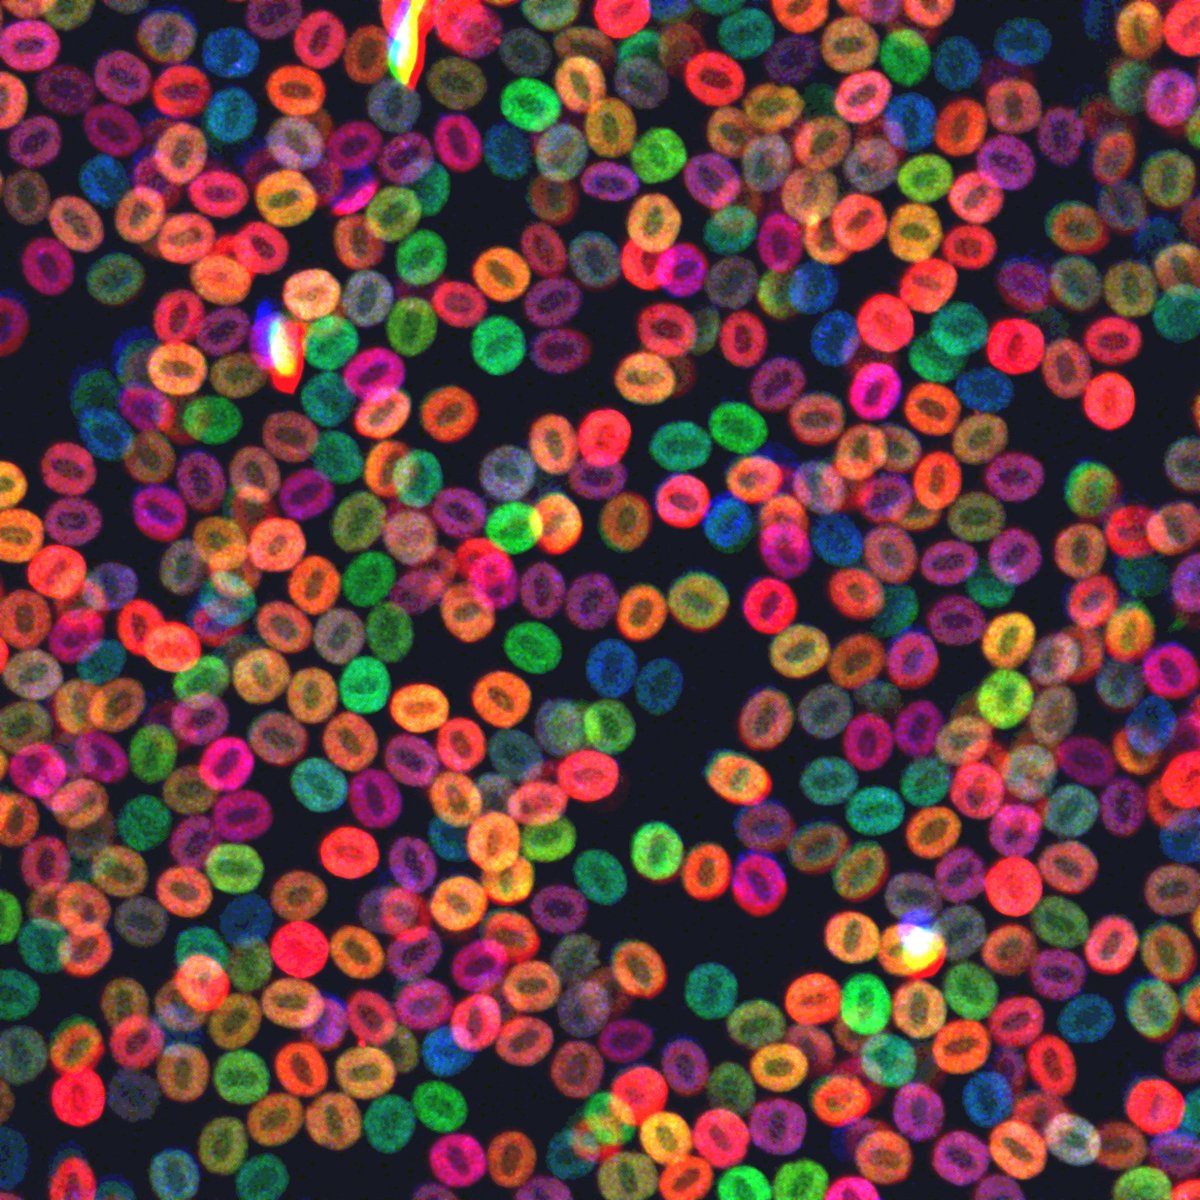

Dr. Square
@dr_tsquare
Assistant Professor in the Department of Microbiology and Cell Science at UF IFAS
ID: 327216984
http://tylersquare.net 01-07-2011 05:37:37
2,2K Tweet
237 Takipçi
508 Takip Edilen





There is still time to apply for the 2024 U.S. National Science Foundation-funded #REU Summer undergrad program: Accessible Sharks! Applications due Jan 19th. Interested in sharks, evodevo, paleontology, and bio-inspired design? Apply to work with labs from @harvard Woods Hole Oceanographic Institution (WHOI) and FLORIDA #NSF #disabledinSTEM 🦈🦈🦈


The Square Lab UF Microbiology is hiring a lab tech! Come help me finish some cool projects on tooth and bone development, start some new experiments, and have a hand in getting my fresh lab up off the ground! DM me if you have any questions. Apply here: explore.jobs.ufl.edu/en-us/job/5300…








The Square Lab UF Microbiology is seeking a postdoc! How is bone size controlled? Which signaling cascades position the dentition? Why do some skin organs regenerate, but not others? Come help me answer these questions!! Apply here: explore.jobs.ufl.edu/en-us/job/5310…